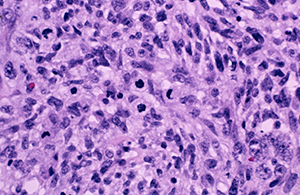
Undifferentiated malignant glioma cells in a cross-section of human brain tissue from the temporal lobe.

Undifferentiated malignant glioma cells in a cross-section of human brain tissue from the temporal lobe.
© Frederick C. Skvara, MD/Visuals Unlimited/Corbis
Malignant glioma is generally a death sentence for patients. These tumors, which arise from non-neuronal cells within the brain, grow quickly and aggressively, and contain a core population of glioma stem cells (GSCs) that are largely invulnerable to the weapons typically brought to bear against other cancers. “GSCs display resistance to radiation due to increased activation of DNA damage repair pathways, and also possess intrinsic resistance mechanisms against chemotherapy-induced cell death,” explains Prabha Sampath of the A*STAR Institute of Medical Biology.
New work from Sampath and her co-workers has revealed a potential vulnerability in GSCs that might give glioma patients a fighting chance. Her team studies microRNAs, tiny RNA molecules that do not encode protein; instead, they govern the production of proteins encoded by other genes. This research has a direct bearing on glioma progression. “MicroRNA-mediated translational control is known to be a major factor in brain tumor pathology,” explains Sampath.
She and her colleagues obtained GSCs from five patients with malignant glioma, and examined how their expression levels of known microRNAs differed relative to normal neural stem cells (NSCs). This revealed that GSCs produce markedly higher levels of the microRNA miR-138; importantly, miR-138 levels dropped when the researchers chemically forced the GSCs to ‘mature’ into differentiated brain cells, supporting a role for this RNA in uncontrolled tumor growth.
Treatment with ‘antimiR-138’, a molecule that selectively blocks the function of miR-138, killed cultured GSCs but had no effect on normal NSCs. Closer examination revealed that the inactivation of this microRNA prevented GSCs from undergoing cell division, and instead caused these cells to undergo a cellular ‘self-destruct’ program.
Subsequent transplantation experiments indicated that this approach might also yield therapeutic fruit: mice that received implants of human GSCs promptly developed aggressive gliomas, but inactivation of miR-138 was sufficient to prevent tumorigenesis. Finally, the researchers demonstrated that elevated miR-138 expression may be predictive of disease recurrence in patients with glioblastoma multiforme (GBM), a typical malignant glioma.
Having established this previously unrecognized role for miR-138 in ensuring GSC survival, Sampath is interested in examining whether this microRNA also contributes to progression and post-therapeutic recurrence of other brain cancers. Even if its influence is limited to a handful of cancers, the clinical impact of these findings could prove very significant. “We are currently performing tumor regression experiments and developing specific vectors for delivery of antimiR-138, with a vision to exploit this further as a novel therapy for treating malignant gliomas,” she says.
The A*STAR-affiliated researchers contributing to this research are from the Institute of Medical Biology.